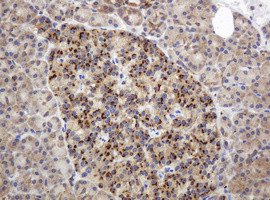
GAPDHS Antibody in Immunohistochemistry (Paraffin) (IHC (P))
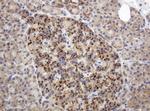
GAPDHS Antibody in Immunohistochemistry (Paraffin) (IHC (P))

Search
OriGene
GAPDHS Monoclonal Antibody (OTI1F6), TrueMAB™
{{$productOrderCtrl.translations['antibody.pdp.commerceCard.promotion.promotions']}}
{{$productOrderCtrl.translations['antibody.pdp.commerceCard.promotion.viewpromo']}}
{{$productOrderCtrl.translations['antibody.pdp.commerceCard.promotion.promocode']}}: {{promo.promoCode}} {{promo.promoTitle}} {{promo.promoDescription}}. {{$productOrderCtrl.translations['antibody.pdp.commerceCard.promotion.learnmore']}}
产品信息
CF505454
种属反应
宿主/亚型
分类
类型
克隆号
抗原
偶联物
形式
浓度
纯化类型
保存液
内含物
保存条件
运输条件
产品详细信息
For reconstitution, we recommend adding 100 µL distilled water to a final antibody concentration of about 1 mg/mL. To use this carrier-free antibody for conjugation experiments, we strongly recommend performing another round of desalting. (Zeba Spin Desalting Columns, 7KMWCO, 0.5 mL, Product # 89882)
靶标信息
Glyceraldehyde 3-Phosphate Dehydrogenase (GAPDH) is a metabolic enzyme responsible for catalyzing one step in the glycolytic pathway, the reversible oxidative phosphorylation of glyceraldehyde 3-phosphate. Because GAPDH is a protein expressed in large amounts and which is required at all times for important "house keeping" functions, levels of GAPDH mRNA are often measured and used as standards in studies of mRNA expression. Increasingly, scientists are making use of specific antibodies to GAPDH in comparable studies of levels of protein expression. GAPDH is reported to bind to a variety of other proteins, including the amyloid precursor protein, mutations in which cause some forms of Alzheimer's disease, and the polyglutamine tracts of Huntingtin, the protein product aberrant forms of which are causative of Huntington's disease. Associations with actin and tubulin have also been reported. The protein may also have a role in the regulation of apoptosis, and interestingly migrates from the cytoplasm into the nucleus when cells become apoptotic.
仅用于科研。不用于诊断过程。未经明确授权不得转售。
篇参考文献 (0)
生物信息学
蛋白别名: epididymis secretory protein Li 278; GAPDH S; GAPDH-2; Glyceraldehyde-3-phosphate dehydrogenase, testis-specific; Spermatogenic cell-specific glyceraldehyde 3-phosphate dehydrogenase 2; Spermatogenic glyceraldehyde-3-phosphate dehydrogenase
基因别名: GAPD2; GAPDH-2; GAPDH2; GAPDHS; GAPDS; HEL-S-278; HSD-35; HSD35
UniProt ID: (Human) O14556
Entrez Gene ID: (Human) 26330